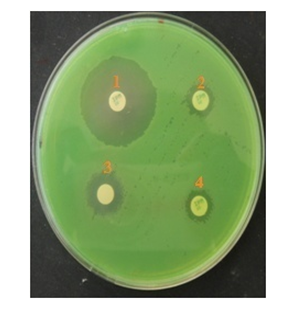

Journal of
eISSN: 2469 - 2786


Research Article Volume 4 Issue 3
1University of Nangui-Abrogoua, C
2Department of Bacteriology and Virology, Institut Pasteur of C
3University of F
Correspondence: Comoe Koffi Donatien Benie, Department of Bacteriology and Virology, Institut Pasteur of Côte dIvoire (IPCI), 01 BP 490 Abidjan 01, Côte dIvoire, Tel +225 07 55 58 44
Received: January 31, 2017 | Published: April 6, 2017
Citation: Benie CKD, Dadie A, Guessennd N, et al. Molecular identification and virulence factors of pseudomonas aeruginosa strains isolated from animal products. J Bacteriol Mycol Open Access. 2017;4(3):91-96. DOI: 10.15406/jbmoa.2017.04.00094
Pseudomonas aeruginosa is an opportunistic pathogen which is characterized by its capacity to develop resistance and virulence factors. Despite their knowledge, these resistance and virulence factors are not more characterized at level of strains from local food. This study aimed to detect the presence of various virulence factors and metallo-β-lactamase-producing P. aeruginosa from animal products. One hundred (100) strains of Pseudomonas aeruginosa were isolated from bovine meat (60), fresh fish (24) and smoked fish (16). API20NE methods, IPM-EDTA disk method and polymerase chain reaction (PCR) using the rpoB, lasB, exoS, algD, and plcH gene were performed. The rpoB gene confirmed 99.0% of presumptive strains as Pseudomonas aeruginosa. All of virulence genes studied were detected in decreasing importance order, lasB (89.0%), exoS (84.0%), algD (73.0%) and plcH (71.0%) (p<0.05). A percentage of 22.0% of animal strains were P. aeruginosa producing MBLs. The simultaneous determination of virulence factors and metallo-β-lactamase is of interest for the efficacy of surveillance of infections associated with P. aeruginosa.
Keywords: pseudomonas aeruginosa, mbls, bovine meat, fresh fish, smoked fish, PCR
Microorganisms are the primary cause of food spoilage and food borne illness.1,2 Among these germs, Pseudomonas aeruginosa occupies a large place in food contamination. It contaminates domestic and wild animals, human beings, plants, drinking water, and is also isolated from variety foods.3,4 This psychrotrophic germ is specific spoilage organisms (SSO) of meat, poultry and fish.4
Pseudomonas aeruginosa is an opportunistic pathogen capable of infecting virtually all tissues.5 It possesses a variety of virulence factors that may contribute to its pathogenicity.5,6 It has also a large number of virulence factors such as, Exo enzyme S, encoded by the exoS gene that is secreted by a type-III secretion system.5,6 Phospholipases C (PLCs) are also implicated in virulence. Pseudomonas aeruginosa produces three PLCs: one with hemolytic activity (PlcH), one other non-hemolytic (PlcN) and the last, a PLcB which is important for chemotaxis and plays an important role in "twiching" mobility.5-7
A phosphate deficiency induces the production of PlcH. These PLCs are secreted via the type-II secretion system.5,6 Others genes are implicated in Pseudomonas aeruginosa virulence: LasB elastase, a zinc metalloprotease encoded by the LasB gene, has an elastolytic activity on lung tissue.5,7 Mucoid colonies composed of alginates produced by Pseudomonas aeruginosa, involving algD genes protect the bacteria from the host immune responses and biocides (antiseptic, disinfectant and antibiotic).6,8
This production of alginates therefore makes the strains of P. aeruginosa multi-resistant. These multi-resistant strains can harbor and produce certain resistance genes such as metallo-β-lactamase (MβL).9,10 Those metallo-enzymes are capable to inactivate β-lactam antibiotics such as carbapenems, penicillins and cephalosporins.10-12 These enzymes promote the involvement of P. aeruginosa in foodborne diseases and nosocomial infections in various regions of the world.2,10,13 The strains of P. aeruginosa metallo-β-lactamase-producing (MβL) are also responsible for serious infections such as septicemia and pneumonia.14 Thus, several phenotypic methods can be used to determine strains of Pseudomonas aeruginosa producing metallo-β-lactamase of various origins.9,15
In addition, PCR allows rapid and complete identification of Pseudomonas aeruginosa .15,16 This method also allows the determination of resistance and virulence genes associated with this bacterium. The relationship between animal products, resistance to antimicrobials and virulence factors of Pseudomonas aeruginosa are not widely studied. This study aimed to detect the presence of various virulence factors and metallo-β lactamase-producing P. aeruginosa.
Isolation of P. aeruginosa from animal products
The studies were carried out in and around market of Abidjan district (Côte d’Ivoire). A total of one hundred (100) isolates of P. aeruginosa were used in the present study. The isolates were obtained from different samples of animal products, including beef (57), fresh fish (23) and smoked fish (18). The samples were collected from local market and put in sterile Stomacher bags, stored at 4˚C, and analyzed within 30 minutes of collection. Ten (10) g of the flesh of each bovine meat, fresh fish and smoked fish sample were homogenized in 90 ml peptone water, and then, serial decimal dilutions were prepared. Amount of 0.1 ml of each dilution was spread on the selective medium Pseudomonas cetrimide agar (PCA) using a spreading technique. Plates were incubated at 44˚C for 18-24 hours and observed for suspected colonies of P. aeruginosa.
Morphological and biochemical characterization
Gram’s reaction- Gram’s staining, Motility determination-Hanging drop method and Motility test were carried out for the morphology of cell. Biochemical identification of the isolates was carried out using API 20NE (bioMérieux, Marcy l’Etoile, France) and the API database.
Phenotypic detection of MBL activity
All strains that showed reduced susceptibility to imipenem ≥8 g/ml were screened for MBL production. These strains were subjected to a phenotypic analysis by EDTA (Sigma Chemicals, St. Louis, MO) combination disk test.17 Briefly, a 18hours culture of animal isolate was diluted with peptone water (Oxoid, USA) corresponded to the 0.5 McFarland standard, which is approximately 108CFU/ml and spread on Mueller-Hinton agar (Oxoid Ltd., Basingstoke, Hampshire, England) plate using cotton swab. Two IPM (10μg) disks were placed on the surface of the agar at distances of 20 mm away from each other. Then, 4μL of EDTA (0.5 M, pH 8) solution was added to one of the IPM (10μg) disks. Another IPM disk (10 μg) was placed at 20 mm center to center of a sterile non-impregnated disk on which 10μl of EDTA (0.5 M, pH 8) has been added.
The inhibition zones displayed around the IPM and the IPM-EDTA disks were compared after 18 to 24hrs incubation at 37˚C. The difference of ≥ 7mm between the inhibition zone diameter of the IPM-EDTA disk and that of the IPM (10μg) alone disk was considered to be a positive test for the presence of MBLs.14 P. aeruginosa PA105663 producing IMP-7; P. aeruginosa PS679/00 producing VIM-2; and P. aeruginosa ATCC 27853 were used as positive and negative controls.
Molecular Identification of Pseudomonas aeruginosa
Extraction and purification of DNA: Template DNA was extracted from whole organisms by boiling.18 Bacteria were harvested from an overnight broth culture (Biokar Diagnostics, BK015HA, France), suspended in 1ml sterile Milli-Q water (milli-Q™, Millipore Corporation, USA). A suspension of 200μl was incubated at -20˚C for 15 minutes and boiled at 95˚C for 15 minutes.
The suspension was immediately cooled at 4˚C for 10 minutes and then centrifuged at 14 000 rpm for 10 minutes to pellet the cell debris. The DNA template was purified according to the method described by Zimmermann et al.19 The purity and DNA concentration of the extract were determined by spectrophotometer (Eppendorf BioPhotometer plus, USA).
PCR amplification
Single PCR for characterization of rpoB gene was carried out with a total volume of 25μl consisted of 16μl of sterile Milli-Q water (milli-Q™, Millipore Corporation, USA), 5μl of 5XTP, 1.5μl of MgCl2 (2mM), 0.2μl of dNTPs (10 mM), 0.1μl of each primer (20mM) (Integral DNA Technology, California, U. S. A) (rpoB F : Order No. 2512433, Ref. No. 70393602; rpoB R : Order No. 2512433, Ref. No. 70393603), 0.1μl of Go tag polymerase (Promega Corporation, Madison, WI 53711-5399, USA) and 2μl of DNA matrix. DNA rpoB region amplification was performed using the primer set rpoB F (5’-CAGTTCATGGACCAGAACAACCCG-3’) and rpoB R (5’ACGCTGGTTGATGCAGGTGTTC-3’), aligning on positions 1552 and 2298 of the rpoB gene sequence of Pseudomonas aeruginosa UCBPP-PA14 (CP000438).20-22
The rpoB DNA was amplified using the following protocol: initial denaturation at 94˚C for 3 min, followed by 35 cycles of denaturation at 94˚C for 1min, annealing at 58˚C for 1 min and extension at 72˚C for 2 min, with a single final extension of 7 min at 72˚C. Amplification was performed with 10µl of PCR products which were separated in 1.5% agarose gel for 30 min at 120V. After amplification, the agarose gel was put in ethidium bromide (0.5μg/ml) and detected by Molecular Imager Gel DocTM EZ (Bio-Rad, USA).
Multiplex PCRs were used to detect lasB, exoS, algD and plcH. PCR mixtures with a final volume of 25μl consisted of 15.8μl sterile Milli-Q water (milli-Q™, Millipore Corporation, USA), 5μl 5XTP, 1.5μl MgCl2 (2mM ), 0.2μl dNTPs (10mM), 0.1μl each primer (20mM) (Integral DNA Technology, France), 0.1μl Go tag polymerase (Promega Corporation, Madison, WI 53711-5399, USA) and 2μl DNA template. A quantity of 2μl of sterile Milli-Q water was used for negative control and DNA of ATCC reference strain 27853 used for positive control.
The oligonucleotide primers used in this study and the amplification program are listed in Table 1. Each PCR was performed using thermocycler type T3000 thermocycler, Block type standard 3a, (Biometra, Germany). The amplified DNA was separated by gel electrophoresis with 2% agarose containing 0.5μg/ml with ethidium bromide for 30min at 130V, visualized under UV transillumination and photographed (Molecular Imager Gel DocTM XR+, Bio-Rad). Amplified genes were identified on the basis of fragment size shown in Table 1.
Primers |
Target |
Sequence (5’-3’) |
Product |
Amplification Program |
Annealing |
Source |
LasB-F |
LasB |
GGA ATG AAC GAG GCG TTC TC |
300 |
94˚C, 5 min |
60 |
|
ExoS-F |
exoS |
CTT GAA GGG ACT CGA CAA GG |
504 |
|||
algD-F |
algD |
ATG CGA ATC AGC ATC TTT GGT |
1310 |
94˚C, 5 min |
62 |
|
plcH-F |
plcH |
GAA GCC ATG GGC TAC TTC AA |
307 |
72˚C, 7 min; 4˚C … |
60 |
Table 1 Primers used for amplification of virulence genes in multiplex PCR
Statistical analysis
The statistical analysis was carried out on the software Statistical Package for the Social Sciences (SPSS) 20.0 (IBM SPSS, Chicago, IL, United States of America) using the Student’s t test, Mann-Whitney U test, Spearman’s correlation analysis and multiple regression analysis. Statistical significance was set at p<0.05.
Morphological and biochemical characterization
Pseudomonas aeruginosa is a motile, Gram negative, facultative, rod-shaped bacterium measuring 0.5 to 0.8μm by 1.5 to 3.0μm in size. It is resistant to high concentrations of salts and dyes, weak antiseptics, and many commonly used antibiotics. Its optimum temperature for growth is 37˚C, but retains a growth potential at temperatures as high as 42˚C. P. aeruginosa strains produce two types of soluble pigments, a fluorescent pigment pyoverdin, and a blue pigment, pyocyanin.
Pseudomonas aeruginosa strains isolated
Out of 112 presumptive isolates of Pseudomonas aeruginosa, 101 (90.1%) were identified by API 20NE (Table 2). The rpoB gene confirmed 100 (99.0%) of these strains as Pseudomonas aeruginosa out of 101 (90.1%) (Figure 1).
Number of Isolates Presumptive P. aeruginosa N=112 |
||
Identification of |
Phenotypic and |
Molecular |
(API 20NE) |
||
Effective (N) |
101 |
100 |
Percentage (%) |
90.1 |
99 |
Table 2 Frequency of strains confirmed by the API 20NE and rpoB genes

Figure 1 rpoB profiles of Pseudomonas aeruginosa isolates. Lanes 1-4; 5-6; 9-10: Presence of Pseudomonas aeruginosa inanalyzed products; Lane 7: Absence of Pseudomonas in analyzed products; CP: Positive control (Pseudomonas aeruginosa ATCC 27853); CN: Negative control; M: Marker Gene Ruler 100 bp (Bench Top, 100 bp DNA Ladder, Promega Corporation, USA). .
Prevalence of virulence genes among all studied P. aeruginosa isolates
Figure 2 to Figure 4 showed that all the virulence genes studied in this study were detected in the 100 strains of Pseudomonas aeruginosa. According to the Figure 2 and Figure 3 lasB gene with 89.0% has been most detected following by exoS (84.0%). The prevalence of algD and plcH gene was respectively 73.0% and 71.0% (Figure 2 & Figure 4).

Figure 2 Prevalence of virulence genes among all studied P. aeruginosa isolates. LasB, elastase LasB-encoding gene; exoS, exoenzyme S-encoding gene; algD, GDP-mannose 6 dehydrogenase AlgD (alginate)-encoding gene; plcH, haemolytic phospholipase C precursor-encoding gene..

Figure 3 Electrophoretic profile of amplification products of virulence genes exoS and lasB in analyzed products. Virulence genes were present in analyzed products, Lane 1,3,5,7,9,10,11 and 12: exoS and lasB; Lane 6 and 8: lasB; Virulence genes were absent in analyzed products, Lane 2 and 4. M: Marker Gene Ruler 250 bp (Bench Top, 1kb DNA Ladder, Promega Corporation, USA); lasB, elastase LasB-encoding gene; exoS, exoenzyme S-encoding gene.

Figure 4 Electrophoretic profile of amplification products of virulence genes algD and PlcH in analyzed products. Virulence genes were present in analyzed products, Lane 1,4,5,7,8,10 and 11: algD and PlcH; Lane 3 and 6: algD; Virulence genes were absent in analyzed products, Lane 2, 9 and 12. M: Marker Gene Ruler 250 bp (Bench Top, 1kb DNA Ladder, Promega Corporation, USA); algD, GDP-mannose 6-dehydrogenase AlgD (alginate)-encoding gene; plcH, haemolytic phospholipase C precursor-encoding gene.
Prevalence of Pseudomonas aeruginosa virulence genes in animal products
The prevalence of virulence genes studied was higher than 50% in all animal products analyzed. The prevalence of lasB and exoS genes was respectively higher in bovine meat (96.7%, 93.3%), followed by smoked fish (87.5%, 75.0%) and fresh fish (70.8%, 66.7%) (Figure 5). That of algD and plcH gene was respectively higher in fresh fish (79.2%, 75.0%) followed by bovine meat (75.0%, 71.1%) and smoked fish (56.3%, 62.5%) (Figure 5).
Metallo-ß actamase and virulence patterns
The strains of Pseudomonas aeruginosa producing elastase (lasB) and harboring the alginate (algD) showed the same percentage of blaIMP genes 73.3% (Figure 6). Those strains whish secreted exoenzyme (exoS) and harboring the alginate (algD) showed the same percentage of blaVIM genes 66.7% (Figure 7). The strains of Pseudomonas aeruginosa harboring the PlcH gene indicated a production of metallo-β lactamase (VIM and IMP) of less than 50% (Figure 6).

Figure 6 Percentage of metallo-β lactamase according to virulence genes of Pseudomonas aeruginosa. MβL Imipenemase (IMP), Verona imipenemase (VIM).
Screening for and confirmation of MBLs
Phenotypic methods indicated that 22 (22.0%) of the 100 strains studied were P. aeruginosa producing MBLs using (Figure 7).
Figure 7 Metallo-β lactamase (MBLs) producing by Pseudomonas aeruginosa isolated from animal products.
The test showed difference of ≥ 7mm between the inhibition zone diameter of the IPM-EDTA disk and that of the IPM (10μg) alone disk. The test was considered to be positive for producing of MBLs. Imipenem (IPM); 1: IMP disks (10μg) + 4μlEDTA (0.5 M, pH 8); 2: IMP disks (10μg) without EDTA (0.5 M, pH 8); 3: non-impregnated disk+ 10μlEDTA (0.5 M, pH 8); 4: IMP disks (10μg) without EDTA (0.5 M, pH 8).
Morphological and biochemical characteristics confirmed that Pseudomonas aeruginosa is a motile (unipolar), gram negative, facultative, catalase positive, oxidative positive, nitrate reduction positive, non-fermentative and rod-shaped bacterium measuring 0.5 to 0.8μm by 1.5 to 3.0μm in size. Its optimum temperature for growth is 3˚C, but retains a growth potential at temperatures as high as 42˚C. P. aeruginosa strains produce two types of soluble pigments, a fluorescent pigment pyoverdin, and a blue pigment, pyocyanin. These results are consistent with those found by Virupakshaiah & Hemalata2 who identified Pseudomonas aeruginosa from food isolates.
Identification of P. aeruginosa has traditionally relied on phenotypic methods. This still is the most accurate standard when dealing with typical isolates of P. aeruginosa. Moreover, biochemical testing takes long time to perform and requires extensive hands-on work by the technologist. Molecular methods have been reported to be superior to the phenotypic methods for identification of P. aeruginosa .5,16 Molecular identification by using rpoB gene showed 100 (99.0%) of the strains were Pseudomonas aeruginosa. This result also indicated the strong discriminating power of the identification method using rpoB gene and confirmed the heterogeneity of the Pseudomonas aeruginosa observed by some authors.5,16 This high molecular identification rate showed that genomic studies are needed to confirm the exact taxonomic position of Pseudomonas aeruginosa.
The results showed also that all the virulence genes studied in this study were detected in the 100 strains of Pseudomonas aeruginosa. Therefore, strains isolated from bovine meat, fresh fish and smoked fish could host these virulence genes studied. Analysis revealed lasB gene (89.0%) and exoS (84.0%) were the most detected in this study and this could be justified by the fact that P. aeruginosa secretes elastase (LasB); a metalloproteinase involved in the host colonization and tissue damage.5 Previous studies have shown a high prevalence of the lasB gene in P. aeruginosa, irrespective of their isolation origin.5,6,24 The prevalence of ExoS observed in this study shows that the strain of Pseudomonas aeruginosa of animal origin could be involved in tissue destruction; ExoS gene is involved in lung infection and may be important for bacterial dissemination.6,7,24
The high prevalence of algD (73.0%) gene observed in this study could be at the origin of the conversion of Pseudomonas aeruginosa strains to a mucoid phenotype overproducing alginates.6,25 This alginate prevalence indicates that isolated strains of animal products are involved in the formation of biofilms as alginates have been widely regarded as the major exopolysaccharides of the biofilm matrix.24,25 The prevalences of plcH (71.0%) gene showed that strains isolated were able of secreting hemolytic exoenzyme and phospholipase C and thus strains could be involved in pulmonary infections.26,27 Our results obtained in this study correlate with those proved by Bradbury et al.28 who proved that P. aeruginosa isolated from nosocomial infections were found to have an increased prevalence of virulence genes.
This study also showed that P. aeruginosa producing elastase (lasB) and harboring the alginate (algD) showed the same percentage of blaIMP genes (73.3%). Those strains whish secreted exoenzyme (exoS) and harboring the alginate (algD) showed the same percentage of blaVIM genes 66.7%. The strains of Pseudomonas aeruginosa harboring the PlcH gene indicated a production of metallo-β lactamase (VIM and IMP) of less than 50%. The prevalence of VIM and IMP was relatively high in the various animal products and therefore animal strains could be involved in serious infections.9,13,29 These same strains could also be involved in zonoses. The detection of virulence factors and metallo-β lactamase in P. aeruginosa can prevent gene mutations and reduce the risk of multiresistance linked to this bacterium.
The simultaneous using of biochemical methods and rpoB genes provides more confident detection of P. aeruginosa by PCR. Determination of different virulence and resistance genes of P. aeruginosa isolates suggests that they are associated with different levels of intrinsic virulence and pathogenicity. Study indicated that MBL-producing isolates were associated with virulence factors and responsible for serious infections. Thus, good practices in hygiene procedures and food preparation are necessary to control and reduce biological risks.
None.
The author declares no conflict of interest.

©2017 Benie, et al. This is an open access article distributed under the terms of the, which permits unrestricted use, distribution, and build upon your work non-commercially.